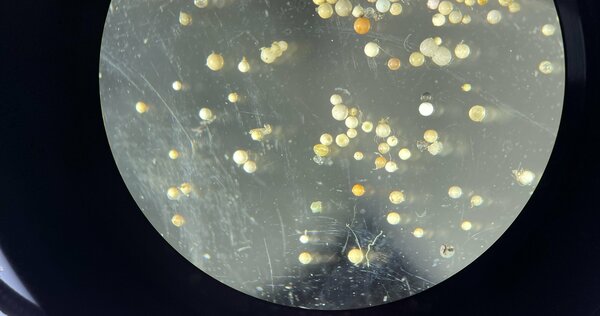

Wasser
Wasser ist eine der grundlegenden Lebensvoraussetzungen für Menschen, Tiere und Pflanzen. In der dicht besiedelten Kulturlandschaft Nordrhein-Westfalens bedarf es besonderer Anstrengungen, um Oberflächengewässer und Grundwasser als Lebensgrundlage und Bestandteil des Naturhaushaltes sowie als Ressource für die Trinkwasserversorgung zu erhalten. Die Erfassung des Wasserhaushalts sowie die ständige Überwachung des Zustands der Gewässer gehören hierzu ebenso wie die Anwendung moderner Techniken zum Beispiel bei der Aufbereitung von Trinkwasser und der Reinigung von Abwasser in Kläranlagen sowie beim Umgang mit wassergefährdenden Stoffen.
Dürre, Starkregen, Überschwemmungen – die Auswirkungen des Klimawandels beeinflussen den Wasserhaushalt deutlich und rücken deshalb das Thema Wasser verstärkt in den Fokus. Ob in der Hydrologie, beim Grund- und Trinkwasser, im Hochwasserschutz, bei der Umsetzung der EG-Wasserrahmenrichtlinie, in der Chemie und Ökologie von Oberflächengewässern, bei den wasserwirtschaftlichen Folgen des Braun- und Steinkohlenbergbaus bis hin zum kommunalen und industriellen Abwasser – als LANUK haben wir hier vielfältige Aufgaben.
Aktuelles
Externer Inhalt
Schutz Ihrer Daten
An dieser Stelle haben wir den Inhalt eines Drittanbieters, bspw. YouTube, X, Instagram etc., eingebunden. Bitte bestätigen Sie über den Button, dass Sie damit einverstanden sind, diese Inhalte zu sehen!
Ich bin damit einverstanden, dass mir externe Inhalte angezeigt werden. Damit können personenbezogene Daten an Drittplattformen übermittelt werden. Mehr dazu in unserer Datenschutz.